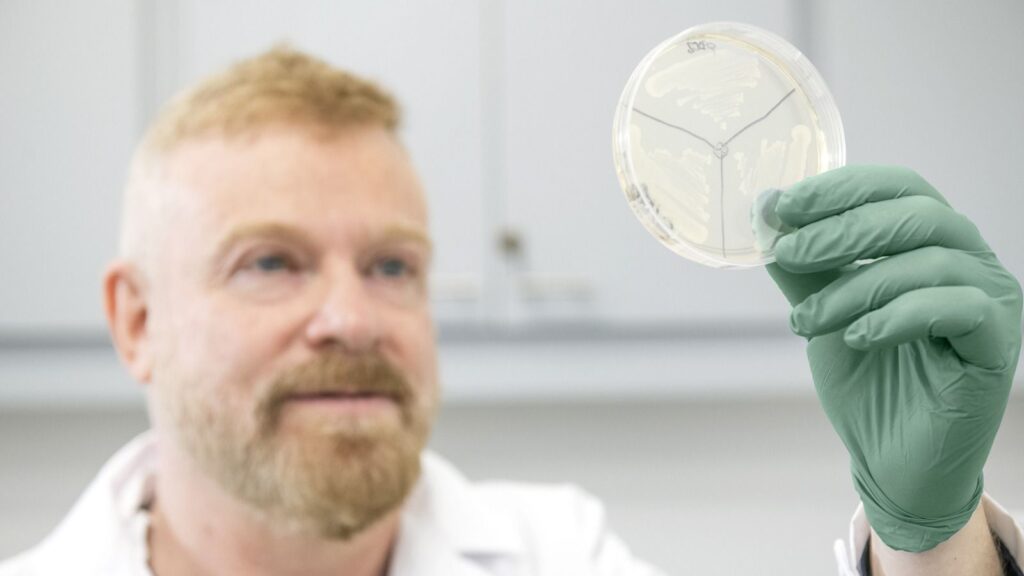

Gabriel Rabinovich, el Messi de la ciencia que juega para Misiones
Hay personas que trascienden su disciplina y se convierten en símbolos universales. En el fútbol, ese lugar lo ocupa Lionel Messi. En la ciencia argentina, el nombre es Gabriel Rabinovich. Y la noticia es que el crack mundial de la investigación contra el cáncer decidió mirar hacia Misiones.

Compararlo con Messi no es un capricho. Rabinovich descubrió la proteína Galectina-1, un hallazgo que lo llevó al radar del Nobel y abrió nuevas puertas en la lucha contra el cáncer y las enfermedades autoinmunes. Su startup, Galtec, ya transforma esos descubrimientos en terapias con impacto potencial en millones de vidas. Es un científico de frontera que podría trabajar en cualquier laboratorio del mundo, pero que elige vincularse con esta provincia.
El convenio en gestación entre su equipo y Misiones tiene tres pilares: educación, investigación y ensayos clínicos. Educación para inspirar a jóvenes estudiantes y residentes médicos a lanzarse a la carrera científica. Investigación para trabajar con muestras de pacientes oncológicos en instituciones locales de referencia como el Hospital Madariaga y el Instituto Misionero del Cáncer. Y ensayos clínicos para que el conocimiento se convierta en esperanza concreta para los pacientes.
Nada de esto sería posible sin un ecosistema preparado. Rabinovich lo dijo con claridad: la infraestructura, el talento humano y la visión de la dirigencia misionera lo convencieron de que aquí se puede dar un salto cualitativo. La ciencia no es un gasto, es una inversión. Lo entendieron países como Corea o Estados Unidos, y Misiones empieza a caminar esa senda con decisión.

La analogía con Messi cobra más fuerza: así como el capitán de la Selección llevó a la Argentina a lo más alto, Rabinovich puede ser el jugador decisivo en la batalla contra el cáncer. Y que esa jugada se prepare en suelo misionero no es un dato menor: es un orgullo y una oportunidad histórica.
La conclusión es simple: el futuro se construye con talento, conocimiento y visión estratégica. Cuidar y potenciar a nuestros científicos es tan importante como alentar a nuestros ídolos deportivos. Porque puede que la próxima gran victoria argentina no llegue en un estadio, sino en un laboratorio. Y Misiones ya se animó a jugar ese partido.
Foto de portada: Diana Martinez Llaser












